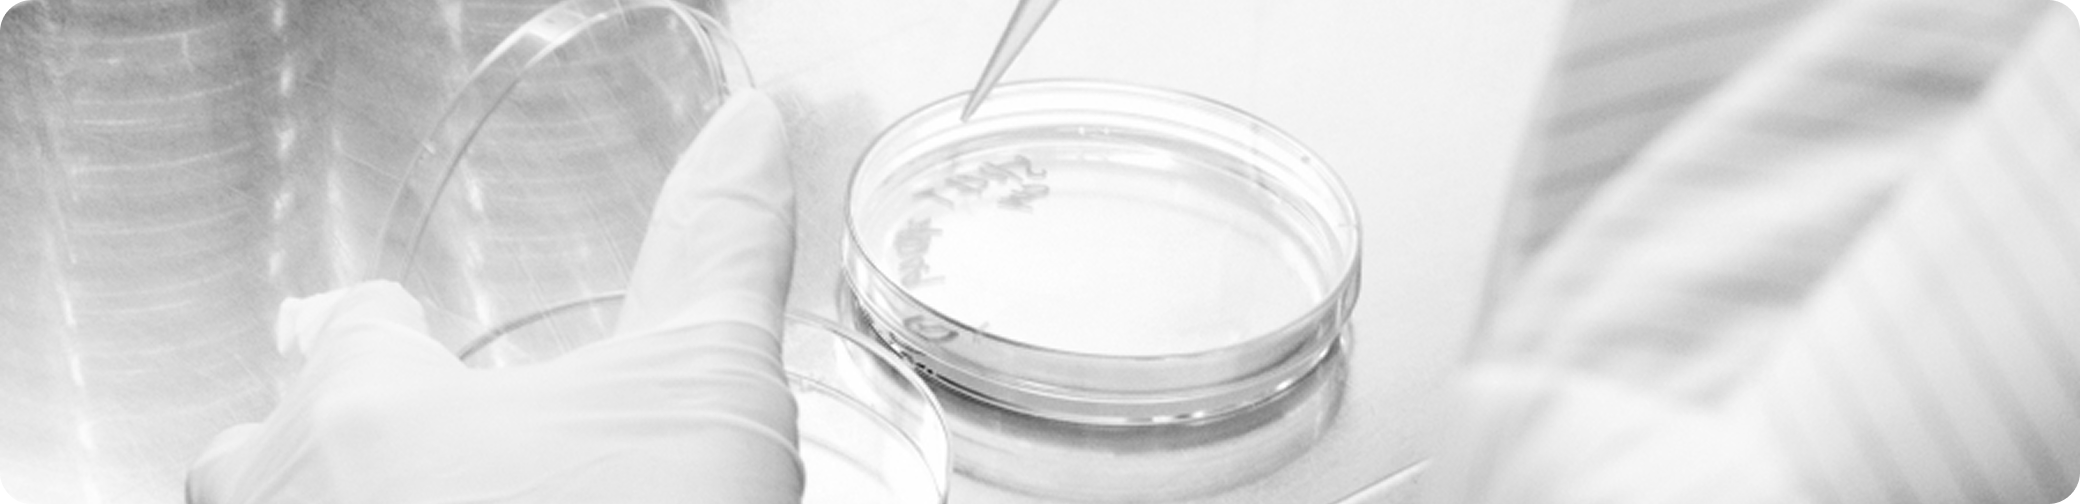

연혁
이미인은 끊임없이 혁신하며
변하지 않는 본질에 집중해왔습니다.

뷰티 혁신을
향한 여정
현재 - 2019

이미인의 첫 산학 장학생 선발
- 2024
-
- 마이크로니들 MOU 체결
- ‘Make up In LA’ 참가
- ‘COSME Week (TOKYO) 2025’ 참가예정
- 마이크로니들 MOU 체결
- 2023
-
- 하이드로콜로이드 MOU 체결
- ‘Make up In NY’ 참가
- 2021
-
- 제 48회 상공의 날-대통령표창 (김주원 대표)
- 2021년 마케팅 트렌트(ACT21) ‘스킨스크래치' 발표
- 2020
-
- 2020년 마케팅트렌드(ACT20) ‘스킨 데미지’ 발표
- 2020.05월 EVE VEGAN 인증 완료 및 EVE VEGAN 제품생산 출시 (제품명 : LALARECIPE glow face moisture mask)
- 의약외품 제조업 식약처 허가획득
- 의약외품 브랜드 세니덤(SENIDERM) 출시 및 한국 의약외품/US OTC/EU CPNP 허가완료
- 한-인도 FTA 품목별 인증 完 (시트/겔/기초)
- 덕용 하이드로겔 아이패치 라인 구축
- 2019
-
- ㈜코디와 MOU 체결
- 2019 홍콩 코스모프로프
- 아시아 전시회 7년 연속 참가
- 2019 볼로냐 코스모프로프
- 유럽 전시회 4년 연속 참가
- 2019 차이나 뷰티 엑스포 참가(7년 연속)

글로벌 스킨케어
기업으로의 도약
2018 - 2015
- 2018
-
- 2018 시트마스크 자동화 기계 도입
- ‘코스모프로프 볼로냐’ 참가
- ‘코스모프로프 홍콩’ 참가
- ~현재까지
- 2017
-
- 중국 항주 미세대 합작 법인 설립
- 코스모프로프 월드와이드 볼로냐 2017 뷰티박람회 참가
- 2017 홍콩 코스모프로프 아시아 전시회 참가
- 2017 차이나 뷰티 엑스포 참가(5년 연속)
- 이미인 랩스 이미인으로 합병
- 2016
-
- 2016 홍콩 코스모프로프 아시아 전시회 참가
- 제 53회 무역의 날 5백만불수출의탑 수상업체 선정
- 이미인 랩스 설립
- 이미인 랩스 CGMP 인증
- 한-중국 FTA 품목별 인증 完 (시트/겔/기초)
- 2016 볼로냐 코스모프로프 유럽 전시회 참가
- 2015
-
- 2015 홍콩 코스모프로프 아시아 전시회 참가
- 제 52회 무역의 날 5백만불수출의탑 수상업체 선정
- 2015 아모레퍼시픽 SCM 협력사 동반성장 총회 ODM 분야 최우수상 수상(4연패)
- ISO22716 인증
- 한-EU & 한-아세안 FTA 품목별 인증 完 (시트/겔/기초)
NO.1
마스크 & 하이드로겔
기업으로 성장
2014 - 2011

이미인의 첫 산학 장학생 선발
- 2014
-
- 미국 뉴욕 소호 한국화장품 플래그십스토어 제2차 개관 홍보 행사
- 중국 항주공장협업 계약 완료
- AMF 겔 IRSI 임상완료
- 아모레퍼시픽 OEM/ODM 최우수업체 선정
- 2014 경기도 하반기 일자리우수기업 인증제 기업 선정
- 2013
-
- 2013 홍콩 코스모프로프 아시아 전시회 참가
- 뉴욕 맨해튼 중소 화장품업체들의 공동 홍보관 운영
- 아모레퍼시픽 OEM/ODM 최우수업체 선정
- 2013 화장품의 날 대한화장품협회장 감사패 수상
- 모범납세자 감사패
- 2012
-
- 국내 마스크팩 제조 업체 최초 CGMP 인증
- 아모레퍼시픽 OEM/ODM 최우수업체 선정
- 한국보건산업진흥원 말레이시아 쿠알라룸푸르 '한국 화장품 상설 전시 · 판매 · 홍보관' 참여
- 2012 경기유망중소기업 선정
- 중소기업기술혁신협회 ‘2012 취업하고 싶은 기업’ 으로 선정
- 2011
-
- 아모레퍼시픽 OEM/ODM 우수업체 선정

새로운
도전의 시작
2010 - 2006
- 2010
-
- 국내 최초 마스크팩 부분 식약청 CGMP 적합업소 기업 지정
- 아모레퍼시픽 OEM/ODM 최우수업체 선정
- 기업부설 연구소 인증서 획득
- 올리브영 입점
- 2009
-
- ISO 9001 / ISO 14001 갱신 획득
- 네이처리퍼블릭, 스킨푸드 마스크 업체 선정
- 기술혁신 중소기업(INNO-BIZ) 확인서 획득
- 2008
-
- ㈜더페이스샵, ㈜코리아나, 리리코스 (프랑스) 마스크 업체 선정
- ㈜아모레퍼시픽과 공동특허 개발한 3중 다층 천연셀룰로오스 부직포 제품화
- ㈜태평양제약과 메디컬 어플리케이션 제품화
- 연구개발 전담부서 인증 획득
- 벤처기업인증 획득
- 2007
-
- ㈜아모레퍼시픽 기술전략 파트너 선정
- 2006
-
- 이미인 법인 설립
- ISO22716 인증
- ISO 9001/ISO 14001 획득